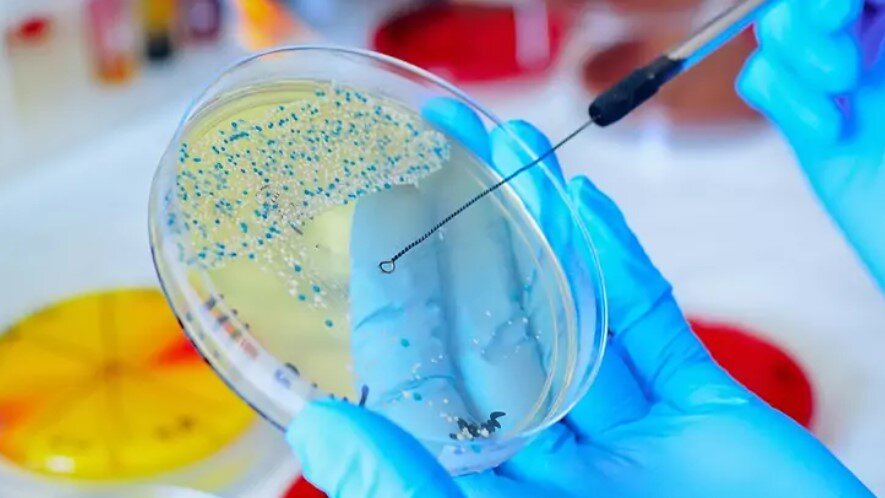
Zygota

Przejdź do sekcji menu główne
Przejdź do sekcji menu boczne
Przejdź do sekcji treść strony
Przejdź do sekcji stopka strony
- Książka telefoniczna
- Wydziały urzędu
- Wykaz kont
- Petycje
- Podatki i opłaty lokalne
- Procedury urzędowe
- Urząd Stanu Cywilnego
- Jednostki organizacyjne
- Nieruchomości
- Konkursy i wyniki
- Praca w UM i jednostkach
- Informacja publiczna
- Deklaracja dostępności
- VAT Centralny
- Monitoring wizyjny
- Zmiana w doręczaniu decyzji podatkowych
Polecamy: